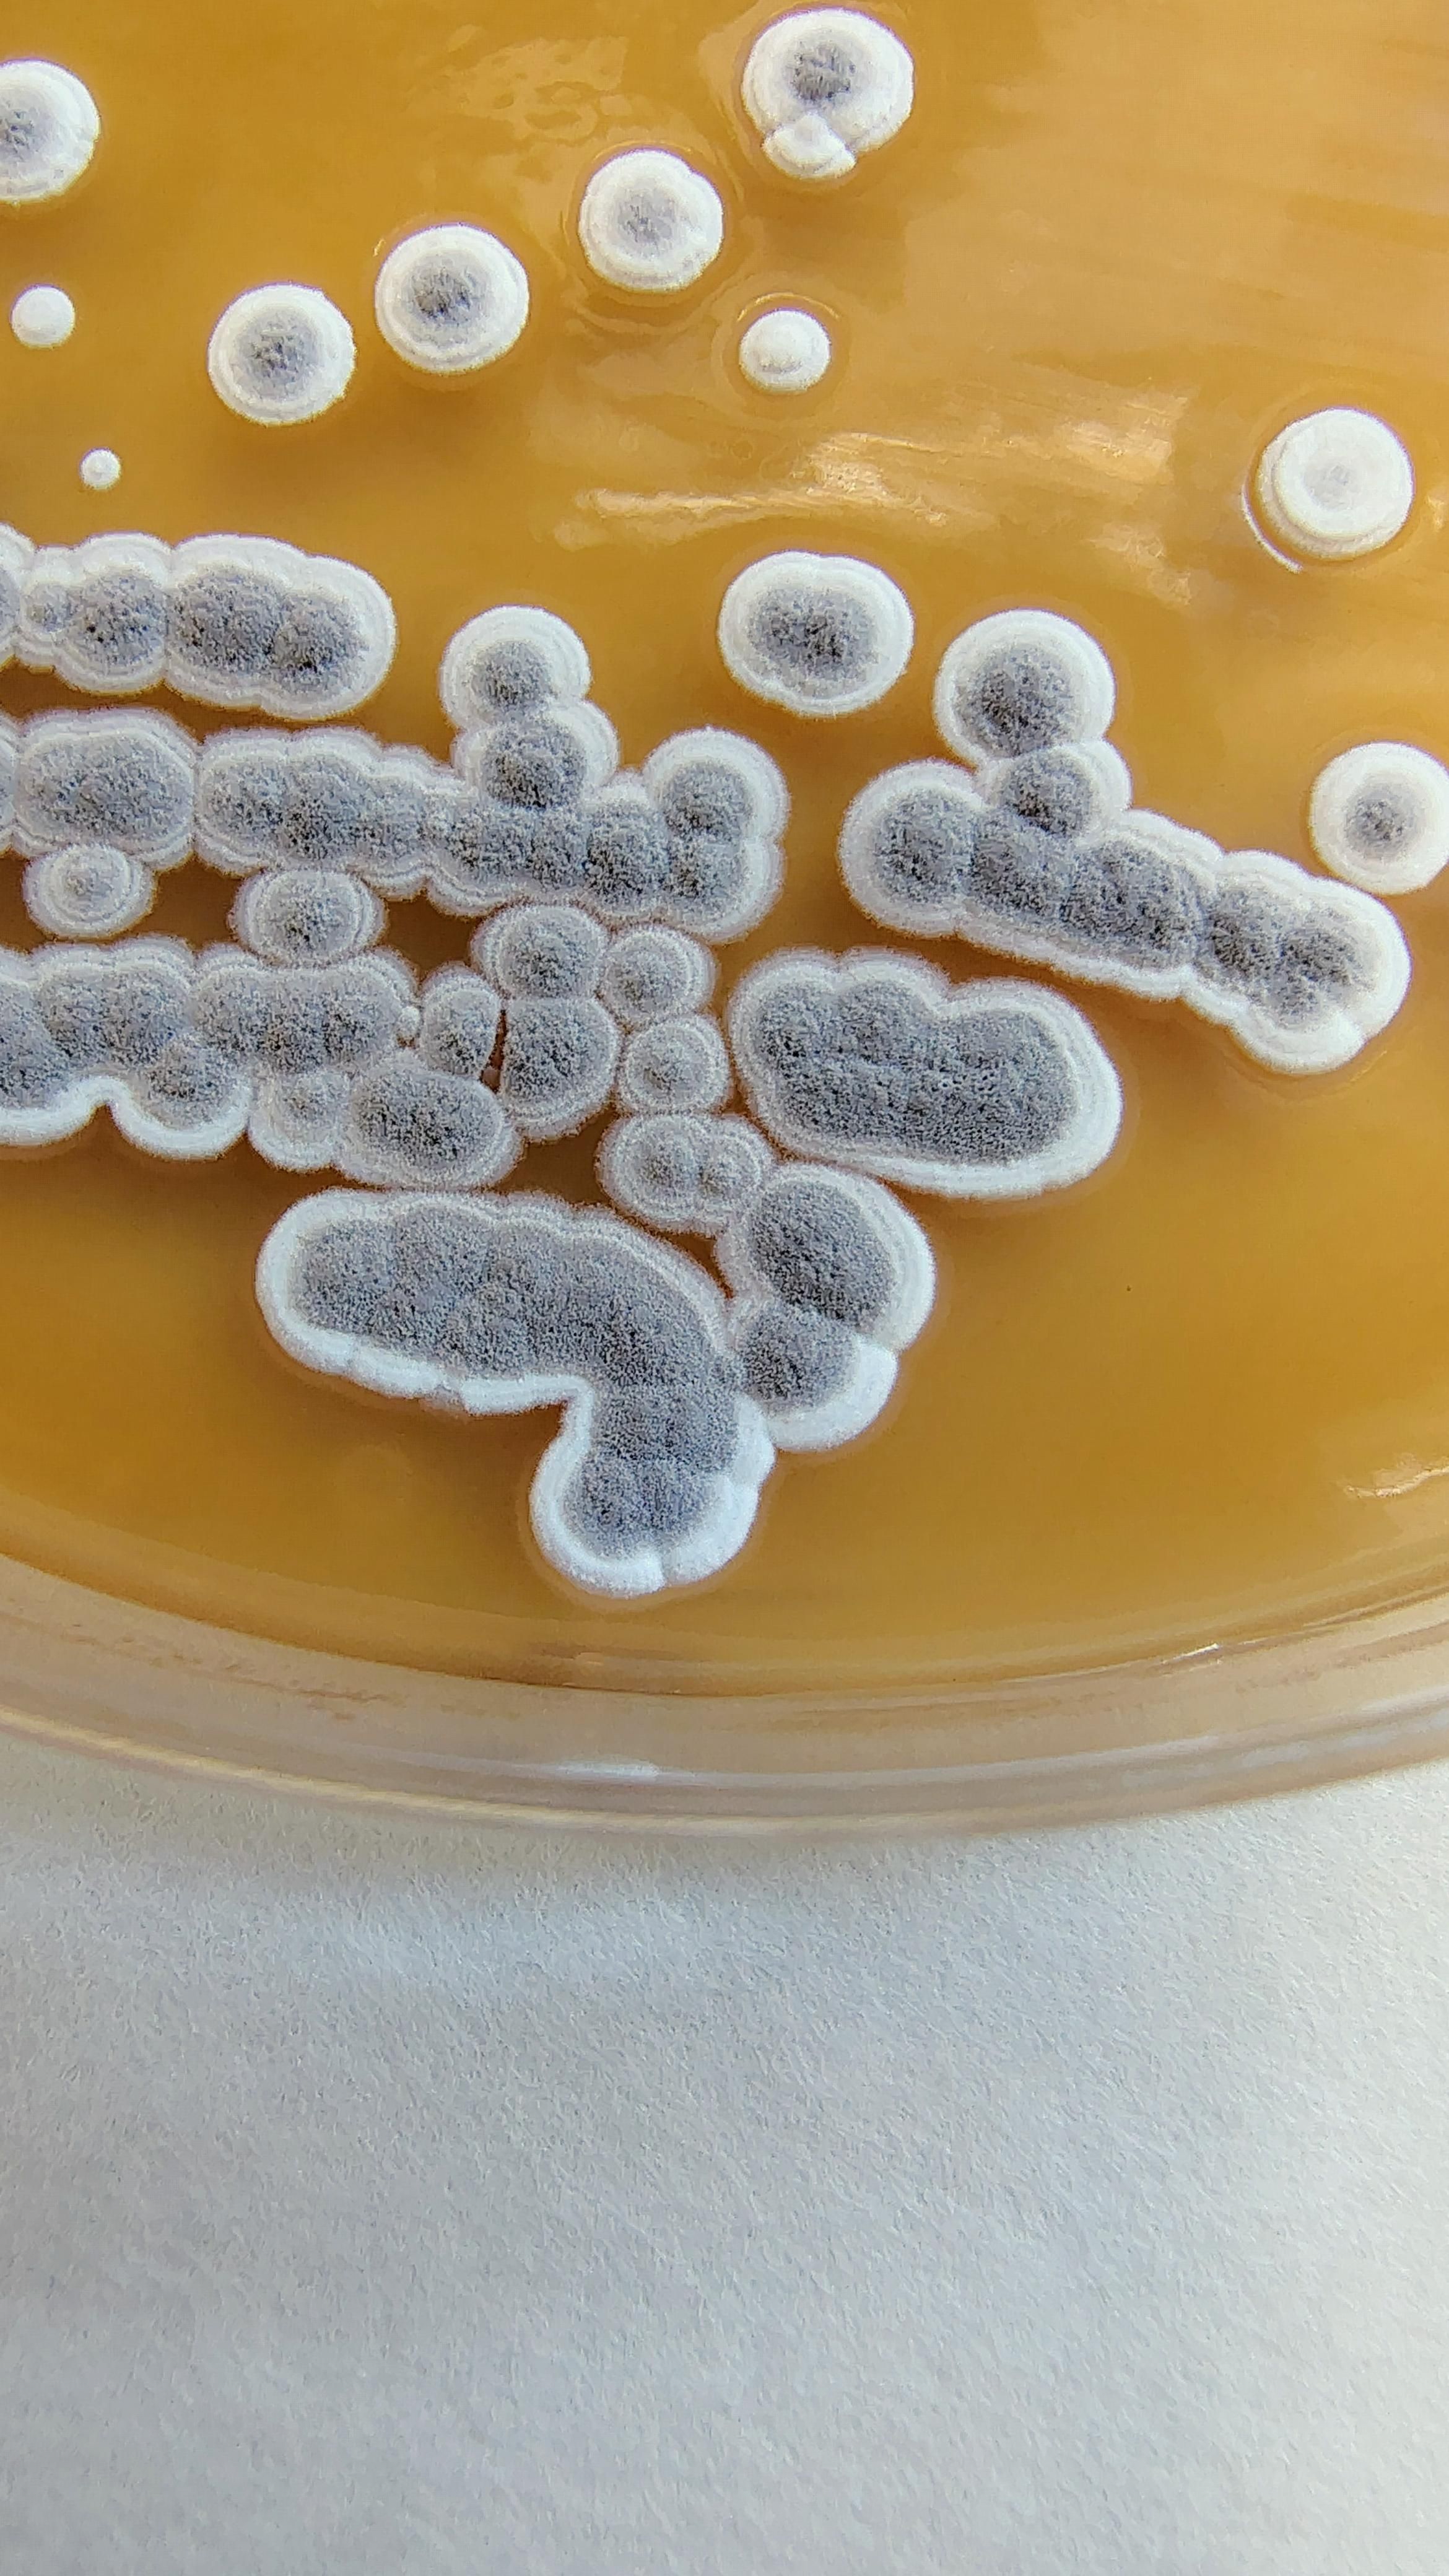
Imagen del crecimiento de las bacterias en una placa de cultivo

Residuos de la industria papelera o del marisco transformados en fertilizantes o apósitos para las heridas

Sustituir los procesos químicos contaminantes por alternativas biológicas que permitan revalorizar residuos vegetales o restos de animales desechados por la industria y reducir el impacto ambiental. Hoy en día es una de las numerosas aplicaciones de la llamada biotecnología ambiental.
José Manuel Molina es profesor del Departamento de Biomedicina y Biotecnología en la Unidad docente de Microbiología de la Universidad de Alcalá y explica que la respuesta está en las aplicaciones biotecnológicas de los microorganismos.
Ahora se investiga cómo los microorganismos pueden conseguir transformar ciertos residuos vegetales o animales - que hasta ahora se tiraban o se quemaban- en productos de alto valor.
El primer paso para lograrlo, comenta este profesor natural de Manzanares, en Ciudad Real, fue estudiar componentes de los vegetales como la celulosa o la lignina, averiguar cómo separarlos y aprovechar su potencial.

“Por simplificar, la celulosa es como la suma de ladrillos que ayudan a construir la planta, y hay otro material que actúa como cemento, que es la lignina”, explica el profesor. En la materia vegetal, la celulosa aporta estructura, es una buena fuente de energía y está protegida por la lignina frente a ataques de organismos invasores, hasta tal punto que es la razón por la que los residuos vegetales tardan más tiempo en descomponerse que un residuo animal.
Históricamente se ha trabajado mucho en intentar recuperar la celulosa y eliminar la lignina. La cuestión es que siempre se han utilizado métodos químicos muy contaminantes, para después además desechar la lignina.
Ahora el camino es otro gracias al papel de los microorganismos, sus enzimas en concreto, capaces de transformar la materia vegetal muerta de forma natural mediante un proceso biológico menos agresivo.
De residuos a recursos: un cambio de paradigma
Los científicos de la universidad alcalaína llevan más de 20 años investigando sobre los microorganismos como “herramientas biológicas muy versátiles a la hora de eliminar contaminantes”, explica.
José Manuel Molina detalla que, tras años de investigar cómo lograr la degradación biológica de las moléculas, se ha dado un giro de 180 grados. Hay un cambio de paradigma que va de la degradación a la valorización. “Ahora trabajamos en el hecho de que los microorganismos son capaces de degradar, pero también de ayudar a crear nuevas moléculas o transformar las que existen”.
Los residuos de la industria papelera han sido uno de los focos de la investigación. La lignina, considerada durante años un estorbo en este tipo de industria, que la eliminaba para obtener el característico color blanco del papel, se ha revelado como una materia prima con un enorme potencial.
La irrupción de la economía circular y una mayor concienciación con la necesidad de preservar el medio ambiente llevaron a la necesidad de dar aplicación al residuo de lignina. “Hemos comprobado que es un material que puede integrarse en otros para dar lugar a productos de valor añadido”.
Por ejemplo, gracias a la acción de microorganismos, puede integrarse en bioplásticos para generar envoltorios alimentarios más resistentes, flexibles y completamente biodegradables.
La Universidad de Alcalá trabaja en este aspecto y ya ha publicado algunos de sus resultados. “Este material no persiste en el medioambiente, como sucede con los plásticos derivados del petróleo. Así es mucho más interesante para utilizarlo masivamente a nivel industrial”, subraya el investigador quien reconoce que todavía es pronto para sustituir la producción de plásticos de origen fósil (a base de petróleo) por plásticos biodegradables.
El exoesqueleto de los crustáceos, materia prima para fertilizantes
Además de las aplicaciones para desarrollar bioplásticos biodegradables, los científicos han confirmado que la combinación de los residuos de lignina con compuestos obtenidos de los caparazones de los crustáceos ofrece interesantes resultados.
El quitosano es el principal componente del exoesqueleto de ciertos crustáceos. La industria del marisco genera toneladas de este tipo de residuos. “Hay que pensar en todas esas gambas que vienen ya peladas y si lo combinamos con la lignina podemos crear un nuevo material de tipo hidrogel”. Es una especie de gelatina capaz de retener una gran cantidad de agua. “Estamos empezando a estudiarlo como base para desarrollar materiales más avanzados, relacionados con los fertilizantes”, que pueden utilizarse para mejorar la calidad de los suelos.
“Trabajamos con lo que se llama sistemas de liberación controlada, de forma que el fertilizante se libere poco a poco”. De hecho, en la Universidad de Alcalá trabajan en el desarrollo de un modelo propio de hidrogel que permitiría no solo aportar humedad al suelo “de forma que se mejora el crecimiento de las plantas y se minimiza la evaporación, sobre todo en terrenos como los que hay en Castilla-La Mancha, donde hay épocas de escasez hídrica para las plantas, sino conseguir prolongar la disponibilidad del fertilizante para las plantas, minimizando además problemas de contaminación ambiental”.

Apósitos para ayudar a cicatrizar heridas
Otra de las aplicaciones que se estudian combinando la lignina con el quitosano y otros elementos es la creación de apósitos para cubrir las heridas. “La capacidad que tienen estos materiales de retener y de absorber agua, crea un ambiente idóneo para la cicatrización”, explica el científico.
Este tipo de producto se asemeja a las condiciones que aporta el tejido, de forma que, sobre todo en el caso de heridas crónicas, de difícil cicatrización, este tipo de recubrimientos pueden aportar la cantidad de humedad adecuada a la herida.
A eso se suma que la lignina tiene ciertas capacidades antimicrobianas que pueden evitar que esas heridas se infecten y favorecer la cicatrización.
“Ya hay modelos comercializados basados en la idea de materiales tipo hidrogel. Lo que nosotros pretendemos es demostrar que esto también se puede hacer a partir de materiales que proceden de residuos, mejorando sus propiedades y contribuyendo a la economía circular”.
Sobre este blog
Espacio de divulgación científica y tecnológica patrocinado por la Universidad de Alcalá (UAH), con el objetivo de acercar el conocimiento y la investigación a la ciudadanía y generar cultura de ciencia






0